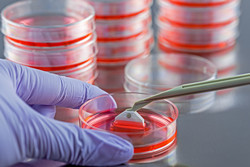

La recherche ciblée sur les cellules souches pour s'attaquer aux maladies dégénératives
Une nouvelle étude, soutenue en partie par le projet PLURIMES financé par l'UE, a réussi une révolution dans le développement de cellules musculaires en laboratoire. L'étude a été publiée dans la revue Nature Biotechnology. Ses auteurs ont utilisé des cellules souches pour développer des fibres musculaires longues d'un millimètre et capables de se contracter et de se multiplier en grand nombre. Les chercheurs espèrent que cette nouvelle méthode apportera un meilleur modèle pour étudier les maladies et tester de nouveaux traitements potentiels. Le projet PLURIMES a été lancé en février 2014 pour découvrir de nouvelles méthodes afin d'orienter le développement de cellules souches en tissu osseux ou musculaire. L'un de ses objectifs était de trouver de meilleurs traitements. Il s'est intéressé aux cellules souches pluripotentes, susceptibles de se différencier pour donner quasiment n'importe quel type de cellule de l'organisme. Les chercheurs estiment que les cellules souches pluripotentes pourraient conduire à de nouveaux traitements pour diverses maladies dégénératives comme la dystrophie musculaire. L'objectif de PLURIMES est particulièrement ambitieux, à savoir développer des options thérapeutiques visant les muscles, les os et le cartilage. Le muscle squelettique est l'un des tissus les plus abondants du corps, mais il est difficile à produire en grande quantité en laboratoire. Contrairement aux cellules cardiaques ou intestinales par exemple, il n'a pas été encore possible de partir de cellules souches pour obtenir efficacement et régulièrement des cellules musculaires. PLURIMES a regroupé des experts dans les cellules souches, le génie génétique, la biologie du développement et la thérapie cellulaire, pour s'assurer que la recherche européenne dans ce domaine reste à la pointe du progrès. L'un des objectifs clés du projet est de créer un système de bio-ingénierie pour orienter la différenciation des cellules souches pluripotentes. La collaboration étroite entre les partenaires sera optimisée via des ateliers de spécialiste et des programmes d'échange entre laboratoires. Le projet concevra des marqueurs fluorescents pour suivre les cellules vivantes et permettre une analyse détaillée, afin d'obtenir des résultats concrets. Il mettra aussi en œuvre des approches sophistiquées de bio-ingénierie. La participation de PME permettra d'optimiser des systèmes innovants de culture de cellules. Les travaux et leurs résultats permettront d'évaluer la capacité des cellules souches pluripotentes à se différencier en muscles squelettiques, en os ou en cartilage. Les tests auront lieu in vitro et in vivo, et le potentiel sera évalué sur des modèles précliniques des maladies. Le projet PLURIMES recevra de l'UE près de 6 millions d'euros. Il s'achèvera en janvier 2018. Ce projet fait partie du programme de recherche SANTÉ de la Commission européenne, qui a récemment accordé 42 millions d'euros aux projets de recherche sur les cellules souches. Pendant son activité, PLURIMES veut établir des relations étroites avec d'autres consortiums financés par l'UE, et a déjà mis en place des collaborations plus étroites avec trois autres projets. Ces projets ont un thème commun, la compréhension de l'auto-renouvellement et de la différenciation des types de cellules souches convenant à diverses thérapies cellulaires. Pour plus d'informations, veuillez consulter: PLURIMES https://www.plurimes.eu/(s’ouvre dans une nouvelle fenêtre)
Pays
Royaume-Uni